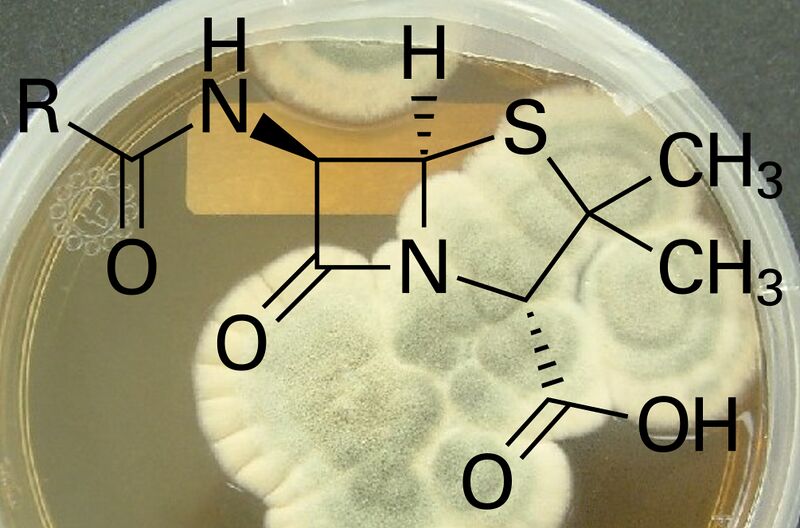
Datei:Penicillin.JPG
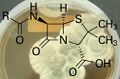
Vorschaubild der Version vom 22:07, 19. Jul. 2025

Dies ist ein ReadOnly-Mirror von wiki.piratenpartei.de!
Die Daten werden täglich aktualisiert.
Die Daten werden täglich aktualisiert.
Datei:Penicillin.JPG
Zur Navigation springen
Zur Suche springen

Größe dieser Vorschau: 800 × 528 Pixel. Weitere Auflösungen: 320 × 211 Pixel | 1.005 × 663 Pixel.
Originaldatei (1.005 × 663 Pixel, Dateigröße: 463 KB, MIME-Typ: image/jpeg)
Beschreibung
Importing file
Dateiversionen
Klicke auf einen Zeitpunkt, um diese Version zu laden.
| Version vom | Vorschaubild | Maße | Benutzer | Kommentar | |
|---|---|---|---|---|---|
| aktuell | 22:07, 19. Jul. 2025 | | 1.005 × 663 (463 KB) | Maintenance script (Diskussion | Beiträge) | == Beschreibung == Importing file |
Du kannst diese Datei nicht überschreiben.
Dateiverwendung
Keine Seiten verwenden diese Datei.